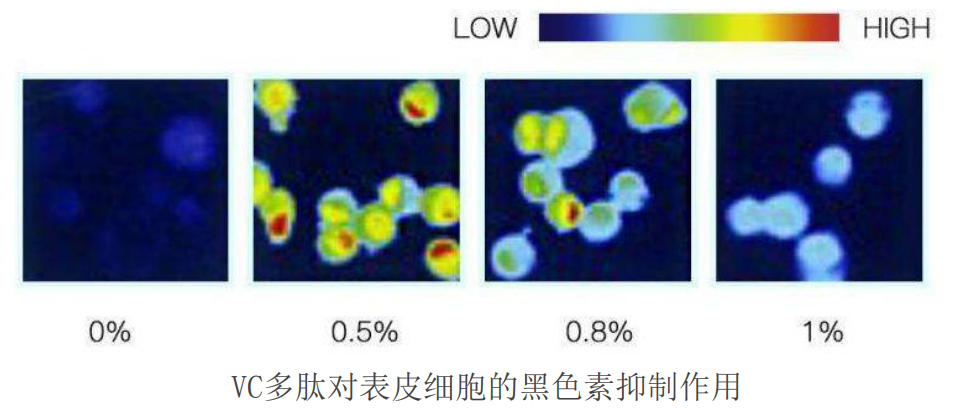
https://image.ipaiban.com/upload-ueditor-image-20210302-1614678090365036589.jpg

清明假期刚过,五一小长假又来让人不淡定了~
向来以为,源源不断的节日,是我们打工人的盼头,但一入电商之后,对挖掘产品的欲望比找对象还强烈,放假是神马?所以今天这篇有什么花头可以搞的么?看到这里你就知道,有了~
你们要的米蓓尔爆款来了
而且全是抄底价

作为全球最大的玻尿酸原料供应商,大名鼎鼎的华熙生物旗下的亲女儿品牌,说米蓓尔是国货之光不为过吧?产品口碑可以说是所向披靡,超多姐妹都是它的自来水:

今天糖糖给大家上架+返场的几款,也是反反复复在电商团队内试用,除了我之外还有@达达 @十一 @袖袖 @小伍 一致反馈“好用”的几个,要知道,我们这些人可是干皮、混干、混油、大油田、超级大干敏皮=全肤质的代表!话不多说,福利先上桌:
对米蓓尔的产品了如指掌的小伙伴,可直达专场购买


米蓓尔轻龄紧致修护面膜
早在去年的时候,就有不少小伙伴来推荐这款蓝绷带面膜,【对它的评价可谓是亮点颇丰】:
我心目中的涂抹面膜top1诞生了!
昨天还因为过敏糙糙的脸今天就好了百分之七十!
光是使用感就属于一骑绝尘了!
这瓶性价比真是太高了,我怀疑它赔钱但是我没有证据!


慕斯质地涂抹起来很顺滑且超级轻盈!
主打成分【愈创木薁磺酸钠】+专利成分【熙敏修™】复配协同,消炎抗敏,加乘缓解肌肤不适,即时舒缓、止痒的效果感觉的到~
复配的【薄荷醇乳酸酯】敷上去凉凉的好舒服!炎炎夏日用应该超爽的吧!
一些带紧致滋润功能的涂抹面膜,痘痘肌、炎症肌肤都会担心太厚重反而更闷痘,但是这个就很好用!

让人意外的是:比其它涂抹面膜更好洗净,不会洗半天还留在脸上洗不掉!
而且洗完皮肤平滑透亮!【牡丹根提取物】&【芍药根提取物】,都具有出色的抗菌效果,除此之外还能配合【孔雀石】促进蛋白酶活性,增强焕肤功效。
细细端详,感觉毛孔也干净了!
配方添加了【亚马逊白泥】收敛去油,量也恰到好处,有一定的吸附油脂作用,但洗完不会出现拨干感,相反非常水当当!嫩嫩润润的,好摸极了!因为有主力选手——Hyamagic-4DHA(4D玻尿酸)的强强联合,保湿能力自然也不是盖的!
使用一段时间后:不仅皮肤没那么容易出油了,肌肤更加细腻了,连毛孔都慢慢隐形了,有核心成分山毛榉紧致精华(玻色因)+【蓝铜胜肽】的加持,对改善细纹干纹、紧致肌肤有一定的功效!








米蓓尔Q-flash冻干固态闪释面膜



修护小蓝膜 

提亮小粉膜

抗糖小紫膜



米蓓尔轻龄紧致能量精华液





米蓓尔轻龄紧致焕亮丝绒霜
排位第五,又补充添加了3%的VC-pro(左旋VC+乙基VC),有提亮肤色的效果,还可以加成抗氧功效!


要知道市面上30%玻色因的修丽可AGE将近2K,黑绷带要3000+,如果你抗衰喜欢玻色因这个成分的话,那这个真的是必入了!


米蓓尔多元修护润养水
(樱花版粉水)

米蓓尔多元玻尿酸精华水
(鸭鸭头蓝水)
120ml市场价198元,活动期间低至98,依旧可叠加:满200减20、满300减30的活动,所以动心的小伙伴还等什么?
滑动查看更多







已同步到看一看
写下你的想法